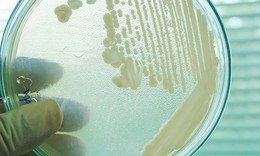
Si&#234;u nấm “giết người” đang lan rộng khắp thế giới

Miền Bắc tăng nhiệt, cảnh báo lũ quét, sạt lở đất vùng núi
Xã hội - 06/07/2026 08:11SKĐS - Ngày và đêm 6/7, Bắc Bộ và Bắc Trung Bộ có mưa rào và dông rải rác với lượng mưa 10-30mm, cục bộ có nơi mưa to trên 70mm; riêng khu vực Tây Bắc Bắc Bộ có mưa, mưa vừa và rải rác có dông.